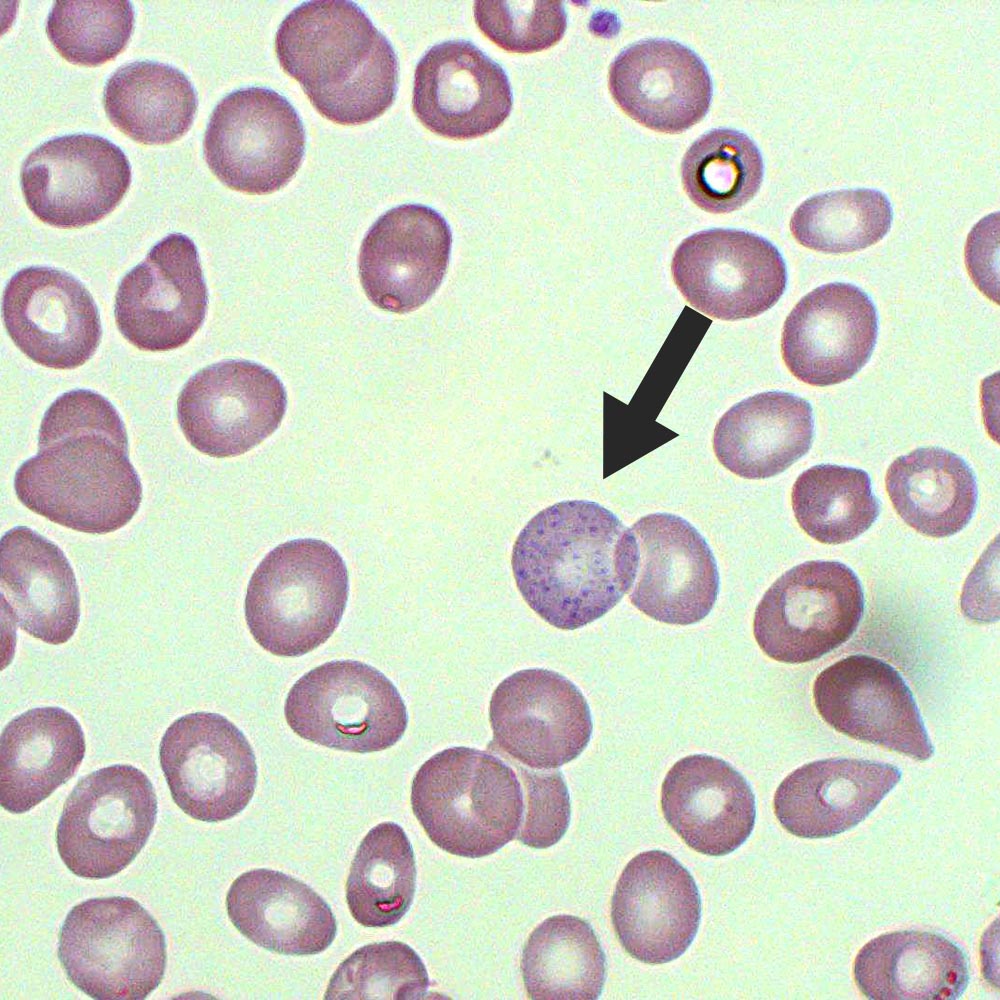
Basophilic Stippling

The soul genre of music is a rich and complex category that has evolved over the years, influenced by various social, cultural, and historical factors. Originating in the 1950s in the United States, soul music is a blend of African American musical styles, including gospel, rhythm and blues, jazz, and funk. The term "soul" refers to the emotional, heartfelt, and often introspective nature of the music, which typically focuses on themes of love, relationships, and social justice.
One of the key characteristics of soul music is its emphasis on vocal performance. Soul singers are known for their powerful, expressive, and often improvisational singing styles, which can convey a wide range of emotions and moods. Some of the most iconic soul singers include Aretha Franklin, known as the "Queen of Soul," James Brown, Marvin Gaye, and Stevie Wonder. These artists have not only helped shape the sound of soul music but have also played a significant role in popularizing the genre worldwide.
Key Points
- Soul music originated in the 1950s in the United States, influenced by African American musical styles such as gospel, rhythm and blues, jazz, and funk.
- The genre is characterized by its emotional, heartfelt, and often introspective nature, with a focus on themes of love, relationships, and social justice.
- Soul music places a strong emphasis on vocal performance, with singers known for their powerful, expressive, and often improvisational singing styles.
- Iconic soul singers such as Aretha Franklin, James Brown, Marvin Gaye, and Stevie Wonder have helped shape the sound of the genre and popularize it worldwide.
- Soul music has evolved over the years, incorporating various sub-genres such as northern soul, southern soul, and neo-soul, each with its unique sound and style.
Evolution of Soul Music

Over the years, soul music has undergone significant evolution, with various sub-genres emerging and influencing the sound of the genre as a whole. Northern soul, for example, is a sub-genre that originated in the 1960s in the north of England and is characterized by its fast-paced, energetic sound and emphasis on rare and obscure soul records. Southern soul, on the other hand, is a sub-genre that emerged in the southern United States and is known for its more laid-back, soulful sound and emphasis on storytelling through lyrics.
Neo-soul is another sub-genre that has gained popularity in recent years, characterized by its blend of soul, R&B, and hip-hop influences. Artists such as Erykah Badu, D'Angelo, and Lauryn Hill have been instrumental in shaping the sound of neo-soul, which often incorporates elements of electronic music, jazz, and spoken word.
Sub-Genres of Soul Music
In addition to northern soul, southern soul, and neo-soul, there are several other sub-genres of soul music, each with its unique sound and style. These include:
- Deep soul: characterized by its intense, emotional sound and often features powerful, soaring vocal performances.
- Quiet storm: a sub-genre that emerged in the 1970s and is characterized by its smooth, soulful sound and emphasis on romantic ballads.
- Psychedelic soul: a sub-genre that combines elements of soul, rock, and psychedelia, often featuring experimental and avant-garde sounds.
| Sub-Genre | Characteristics |
|---|---|
| Northern Soul | Fast-paced, energetic sound, emphasis on rare and obscure records |
| Southern Soul | Laid-back, soulful sound, emphasis on storytelling through lyrics |
| Neo-Soul | Blend of soul, R&B, and hip-hop influences, often incorporates electronic and jazz elements |

Influence of Soul Music on Contemporary Music

Soul music has had a profound influence on contemporary music, with many artists across genres drawing inspiration from the genre’s emotional, heartfelt sound. From R&B and hip-hop to rock and pop, soul music’s influence can be heard in the work of artists such as Kendrick Lamar, Beyoncé, and Adele, among many others.
In addition to its influence on popular music, soul music has also played a significant role in shaping social and cultural movements. The genre's emphasis on themes of love, relationships, and social justice has made it a powerful tool for social commentary and activism, with many soul artists using their music as a platform to address issues such as racism, inequality, and social injustice.
Social and Cultural Impact of Soul Music
Soul music’s impact on social and cultural movements cannot be overstated. The genre has provided a powerful platform for artists to express themselves and address issues of social justice, with many soul songs becoming anthems for civil rights and social movements. The genre’s emphasis on community and collective expression has also made it a powerful tool for building and strengthening social bonds, with many soul artists using their music to bring people together and promote unity and understanding.
What is the origin of soul music?
+Soul music originated in the 1950s in the United States, influenced by African American musical styles such as gospel, rhythm and blues, jazz, and funk.
What are some key characteristics of soul music?
+Soul music is characterized by its emotional, heartfelt, and often introspective nature, with a focus on themes of love, relationships, and social justice. The genre places a strong emphasis on vocal performance, with singers known for their powerful, expressive, and often improvisational singing styles.
How has soul music influenced contemporary music?
+Soul music has had a profound influence on contemporary music, with many artists across genres drawing inspiration from the genre’s emotional, heartfelt sound. From R&B and hip-hop to rock and pop, soul music’s influence can be heard in the work of artists such as Kendrick Lamar, Beyoncé, and Adele, among many others.